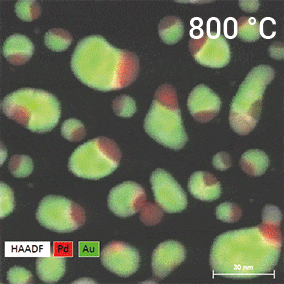
使用DENS新款芯片时,铂/钯纳米颗粒在高温下的能谱结果

引言
在上一篇文章《DENS 透射电镜原位样品杆加热功能 4 大特性解析》里,我们以 DENS Wildfire 原位加热样品杆为例,为大家详细介绍了 DENS 原位样品杆加热功能在控温精准、图像稳定、高温能谱、加热均匀四个方面的具体表现。通过这篇文章,相信大家对 MEMS 芯片的优良性能有更进一步的了解。
DENSsolutions 始终秉持着开放式创新的理念,不断追求产品性能的精益求精,并对细节设计追求完美。在其众多创新设计中,加热芯片的升级改进尤为引人注目。本文将以芯片微加热器的改变为例,与大家深入探讨芯片加热设计具体的变化细节。
01. 加热线圈的变化
1.1 线圈尺寸缩小,“鼓胀”现象得到明显抑制

图 1:新款芯片

图 2:旧款芯片
仔细观察上图中两款芯片的加热区,可以发现新款芯片的加热线圈要明显比旧款小很多。再观察下面的特写视频我们可以看到,加热线圈的形状也有明显变化。新款的是圆形螺旋,旧款的是方形螺旋。
线圈尺寸缩小后,加热功率减小,由加热所导致的“鼓胀”现象也会得到抑制。所谓“鼓胀”是指芯片受热时,支撑膜在 Z 轴方向上的突起。在透射电镜中原位观察样品时,支撑膜的突起会使得样品脱离电子束焦点,导致图像模糊,不得不重新调焦;甚至有时会漂出视野,再也找不到样品。这样一来,就会错失原位变温过程中那些瞬息即逝的实验现象。
从视频 1 中可以看到,新款芯片设计优化之后,“鼓胀”现象几乎被消除了—— 500 ℃ 以内的鼓胀可以忽略不计,即使是加热到 1300 ℃,鼓胀也不足 7 μm。
1.2 加热时红外辐射减少
尺寸缩小、加热功率减小,所带来的另一个好处就是加热时红外辐射减少,从而对能谱分析的干扰就会降低。这意味着即便在更高温度下,依然能够进行稳定可靠的能谱分析。
图 3:使用新款芯片时,铂/钯纳米颗粒在高温下的能谱结果。
1.3 温度均匀性提升
此外,形状从方形变为圆形,优化了加热区域的温度分布情况,温度均匀性更好,可以达到 99.5% 的温度均匀度。

图 4:新款芯片加热时的温度分布情况
02. 电子透明窗口的变化
2.1 电子透明窗口种类多样化
除了线圈尺寸、形状不同之外,新旧两款芯片所用来承载样品的电子透明窗口也明显不同。旧款设计中,窗口都是形状相同的长条,分布在方形螺旋之间。而在新款设计中,窗口种类则更加多样化,根据形状和位置不同可分为三类窗口,适用于不同的制样需求。

图 5:新款芯片中透明窗口分三类,可以适用于不同的样品需求。
红色窗口:圆形窗口,周围宽敞,没有遮挡,适合以各种角度放置 FIB 薄片。
蓝色窗口:位于线圈最中心,加热均匀性最好,周围的金属也可以抑制荷电,适合对温度均匀性要求很高的原位实验,也适合放置易荷电的样品。
绿色窗口:长条形窗口,和 α 轴垂直,在高倾角时照样可以观察样品,适合 3D 重构。
总结
通过以上图文,我们为大家介绍了采用创新设计之后新款芯片的四大优势,全文小结如下:
1. “鼓胀”更小,原位加热时图像更稳定,便于追踪瞬间变化过程。
2. 红外辐射更少,在 1000 ℃ 时,依旧可以进行可靠的能谱分析。
3. 优化线圈形状,抵消了温度梯度,提升了加热区域的温度均匀性。
4. 加热区有三种观察孔,分别适用于 FIB 薄片、超高均匀性受热、大倾角 3D 重构等不同需求。此外,优化后的窗口几何不仅便于薄膜沉积,还可消除滴涂时的毛细效应。这些针对不同需求的细节设计都使得制样更加便捷、高效。
至此,我们关于 DENS 新旧两款加热芯片的对比分析已经结束。大家对微加热器的设计也有了进一步的了解。后续我们会继续推出其他芯片的设计解析,请大家保持关注!

如果您对我们产品感兴趣或者想预约 DEMO,欢迎您识别下方二维码填写需求,我们会在收到您的需求后第一时间联系您。


如果您想要了解更多产品信息,请填写以下信息下载产品手册, 我们收到您的信息后将第一时间回复您。